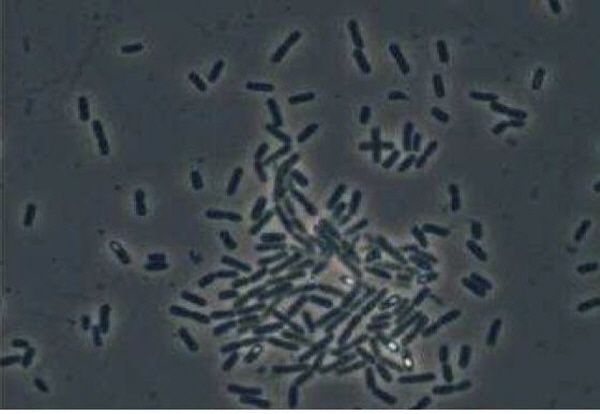
유용 미생물로는 고초균과 광합성균, 유산균, 효모균 등 4종의 미생물

최근 친환경 농업이 확산되면서 농산물에 대한 소비자 인식과 수준이 높아지고, 생산농가들의 안전성 확보 노력도 함께 더해지고 있다. 친환경 농산물 생산농가가 가장 집중하는 부분이 바로 농약과 비료를 대체할 수 있는 유용미생물이다.
경남도농업기술원(원장 강양수)은 금년부터 2018년까지 4년 동안 농촌진흥청과 공동으로 유용미생물의 작목별 활용매뉴얼 확립을 위한 활용기술 지침서 개발 과제를 수행한다.
농기원관계자는"이번 과제가 지침서 개발에만 그치는 것"이 아니라 "일선 시군농업기술센터와 농가 보급 체계를 구축하여 영농현장에 신속 정확하게 활용할 수 있는 시스템을 마련하는 데에도 목적이 있다“고 말했다.
일반적으로 농가에서 활용하는 유용미생물은 작물의 생육 촉진, 병해충 방제, 농업환경 개선(축산 악취 줄임)등을 위해 사용되고 있으며, 대표적인 유용 미생물로는 고초균과 광합성균, 유산균, 효모균 등 4종의 미생물이 이용되고 있다.
지금까지 유용미생물은 시군농업기술센터의 미생물 보급사업의 일환으로 무상으로 공급 되고 있으며, 경남지역에도 통영 등 8개 시군에 보급되어 활용 하고 있다.
경남도농업기술원은 "이번 과제 수행을 통해 지역별 농업기술센터를 배양소로 설정하고, 활용도를 높여 유용미생물의 체계적인 공급과 실질적인 활용을 가능하게 하는 배양시스템을 구축해 나간다“며"농업미생물 제제 수요 증가와 이에 따른 불량제제 출현에 의한 농가 피해를 최소화하기 위해 효용성이 높은 농업미생물을 대량 생산할 수 있는 배지와 배양조건을 개발하는데 주력한다”고 말했다.
경남도농업기술원은 올해 공동과제 수행의 중간 결과물로 작물생육 촉진 미생물인 바실러스 서브틸리스(Bacillus subtilis S37-2) 배양액(106cfu/㎖)을 상추 정식 후 5일 간격으로 5회 주입하였더니 상추 수량이 30%이상 증가한다는 연구결과를 얻어냈다.
이것은 작물이 필요로 하는 미생물을 적절한 농도조건과 시기에 잘만 적용한다면 유용미생물의 효과를 제대로 볼 수 있다는 것을 반증하고 있다.
경남도농업기술원 최용조 친환경연구과장은 “안정적으로 사용할 수 있는 미생물제제를 개발하고, 그 적용방법에 대한 연구를 계속 수행하여, 이들에 대한 지역별 특성 및 작물에 대한 효과검증 및 품질관리 등을 통해 실용화에 앞장설 것 이라“고 말했다.